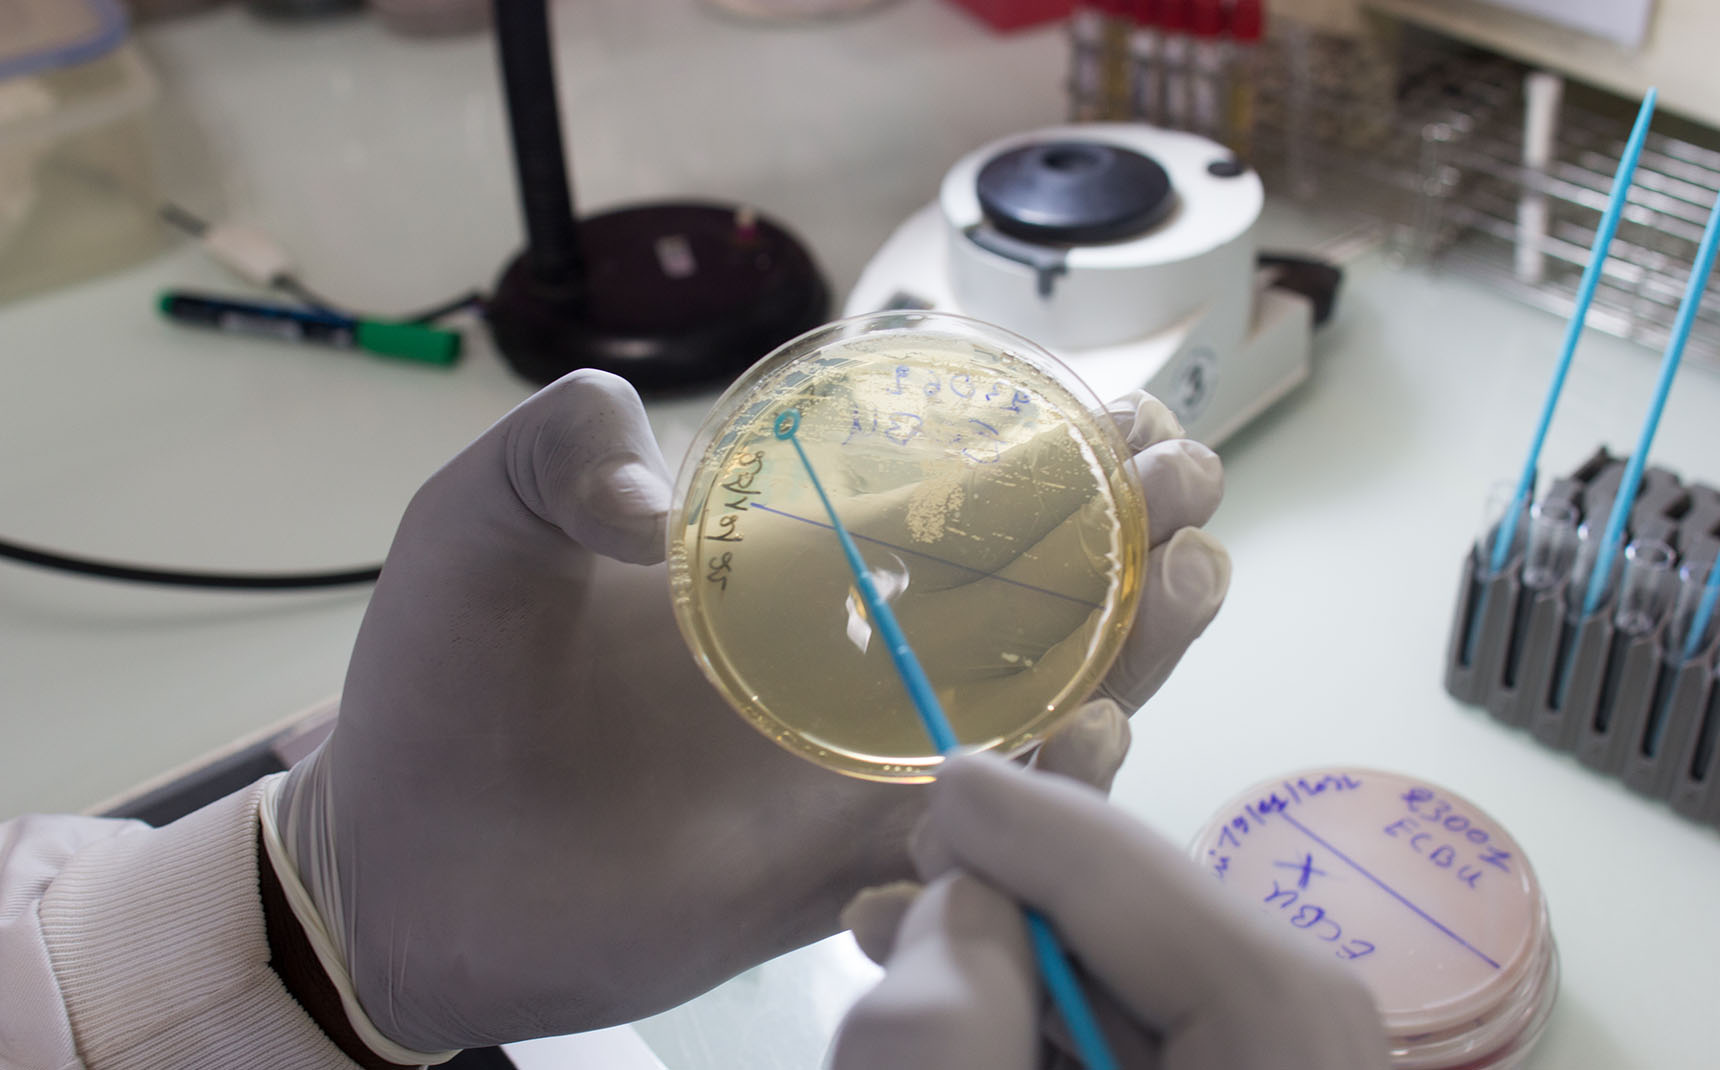
Zoom in on the hands of a lab technician handling a petri dish.

Our priorities
The Mérieux Foundation combats the deadliest infectious diseases, such as tuberculosis and acute respiratory infections, at international level. It prioritizes the fight against antimicrobial resistance and is also committed to addressing the threat of emerging and re-emerging pathogens.
Acute respiratory infections are among the deadliest infectious diseases. Pneumonia is the leading cause of child mortality worldwide, with 99% of deaths occurring in low- and middle-income countries.
Since emerging in December 2019, COVID-19 has claimed nearly 7 million lives globally, with a death rate four times higher in low- and middle-income countries than in high-income nations.
Yet, these diseases are preventable and treatable.

Through the GABRIEL network, the Mérieux Foundation coordinates research programs on pneumonia etiology and incidence, as well as viral and bacterial co-infections. By advancing our understanding of these infections and sharing knowledge globally, these research programs contribute to public health improvements and better disease management. We also conduct research projects to enhance diagnostic access and pneumonia case management in crisis areas and low-income countries, such as in Rohingya refugee camps in Bangladesh.
During the COVID-19 pandemic, the Mérieux Foundation supported laboratories through training, equipment supply, and research initiatives focused on disease transmission. The NOSO-COR study, for example, evaluated the risk of nosocomial SARS-CoV-2 transmission across seven countries, including Bangladesh, where transmission was also studied among Rohingya refugees.
Many respiratory infections can be prevented with better global vaccine coverage. The Mérieux Foundation supports health authorities for the introduction of life-saving vaccines for children in countries where they are not yet systematically administered, such as the pneumococcal conjugate vaccine (PCV) in Chad, Guinea, Somalia, and South Sudan. We also conduct research in countries that have recently introduced these vaccines to better understand their impact in specific contexts.
Since 2022, the Mérieux Foundation has been part of the Every Breath Counts coalition, alongside over 100 organizations from the United Nations, the private sector, NGOs, and academia. Our common goal: to eliminate pneumonia globally by pooling our efforts.
A child dies of pneumonia every
seconds worldwide